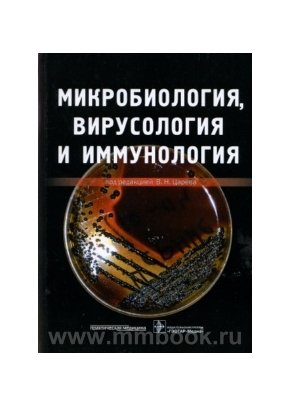
Микробиология

Книги по стоматологии
- Лидер продажНет в наличииколлектив
Протокол ведения больных. Болезни периапикальных тканей
Издательство: Медицинская книга. Артикул: 105252, ISBN: 978-586093-312-131-6, год: 2011, страниц: 116,300 ₽ - Нет в наличииколлектив
Протокол ведения больных. Кариес зубов
Издательство: Медицинская книга. Артикул: 105251, ISBN: 978-586093-311-1, год: 2011, страниц: 76,300 ₽ - Лидер продажНет в наличииколлектив
Протокол ведения больных. Болезни пульпы зуба
Издательство: Медицинская книга. Артикул: 105253, ISBN: 978-586093-310-131-X, год: 2011, страниц: 104,300 ₽ - Нет в наличииГерасимова Л.П.
Рентгенодиагностика в терапевтической стоматологии: Учебное пособие
Издательство: Медицинская книга. Артикул: 105250, ISBN: 978-5-86093-314-2, год: 2011, страниц: 196,200 ₽ - Нет в наличииМамедова Л.А.
Местная анестезия в амбулаторно-поликлинической стоматологии
Издательство: Медицинская книга. Артикул: 105242, ISBN: 978-5-86093-416-0, год: 2011, страниц: 44,100 ₽ - Нет в наличииМакеева И.М.
Восстановление зубов светоотверждаемыми композитными материалами
Издательство: МЕДпресс-информ. Артикул: 105220, ISBN: 978-5-98322-720-0, год: 2011, страниц: 416 с ил,615 ₽ - Нет в наличииОделл У.
Решение проблем в клинической стоматологии
Издательство: Reed Elsevier. Артикул: 105205, ISBN: 978-5-91713-069-9, год: 2011, страниц: 384 с ил,1725 ₽ - Нет в наличииПихур О.Л.
Клиновидные дефекты твердых тканей зубов: учебное пособие
Издательство: СпецЛит. Артикул: 105207, ISBN: 978-5-299-00478-6, год: 2011, страниц: 96,175 ₽ - Нет в наличииКречина Е.К., Козлов В.И.
Микроциркуляция в тканях десны пародонта
Издательство: ГЭОТАР-Медиа. Артикул: 105189, ISBN: 978-5-9704-0636-6, год: 2007, страниц: 80,150 ₽ - Нет в наличииРобустова Т.Г.
Национальное руководство. Хирургическая стоматология и челюстно-лицевая хирургия с CD
Издательство: ГЭОТАР-Медиа. Артикул: 105191, ISBN: 978-5-9704-3727-8, год: 2015, страниц: 928, переплет: твердый2550 ₽ - Нет в наличииДмитриева Л.А.
Современные пломбировочные материалы и лекарственные препараты в терапевтической стоматологии: Практическое руководство
Издательство: Медицинское информационное агентство. Артикул: 105165, ISBN: 978-5-8948-1872-6, год: 2011, страниц: 456,530 ₽ - Нет в наличииЦарев В.Н.
Микробиология, вирусология и иммунология. Учебник для вузов
Издательство: Практическая медицина. Артикул: 105063, ISBN: 978-5-98811-154-2, год: 2010, страниц: 581 с ил,690 ₽ - Нет в наличииСмирнов В. Г., Персин Л. С.
Клиническая анатомия скелета лица
Издательство: Медицина. Артикул: 105030, ISBN: 5-225-03948-0, год: 2007, страниц: 224 с ил,695 ₽ - Нет в наличииДмитриева Л.А.
Национальное руководство. Терапевтическая стоматология с CD
Издательство: ГЭОТАР-Медиа. Артикул: 104995, ISBN: 978-5-9704-1030-1, год: 2009, страниц: 912,1100 ₽ - Нет в наличииКисельникова Л.П.
Национальное руководство. Детская терапевтическая стоматология с CD
Издательство: ГЭОТАР-Медиа. Артикул: 104994, ISBN: 978-5-9704-1703-4, год: 2010, страниц: 896, переплет: твердый1950 ₽ - Нет в наличииИванов А.С.
Основы дентальной имплантологии
Издательство: СпецЛит. Артикул: 104963, ISBN: 978-5-299-00572-1, год: 2013, страниц: 66,120 ₽ - Нет в наличииМурзова Т.В.
Ошибки эндодонтического лечения и пути их предупреждения. Учебно-методическое пособие
Издательство: НГМА. Артикул: 104932, ISBN: 978-5-7032-0775-8, год: 2010, страниц: 48 с ил,120 ₽ - Нет в наличииЛукиных Л.M.
Физиотерапия в практике терапевтической стоматологии
Издательство: НГМА. Артикул: 104920, ISBN: 978-5-7032-1052-9, год: 2015, страниц: 52, переплет: мягкий80 ₽ - Лидер продажНет в наличииЛукиных Л.М.
Чтение рентгенограмм зубов и челюстей в различные возрастные периоды в норме и при патологии
Издательство: НГМА. Артикул: 104921, ISBN: 978-5-7032-1191-5, год: 2017, страниц: 44,100 ₽ - Нет в наличииСёмкин В. А.
Патология височно-нижнечелюстных суставов
Издательство: Практическая медицина. Артикул: 104947, ISBN: 978-5-98811-166-5, год: 2011, страниц: 168 с ил,440 ₽ - Нет в наличииЛукиных Л.M.
Апикальный периодонтит
Издательство: НГМА. Артикул: 104910, ISBN: 978-5-7032-0778-9, год: 2010, страниц: 120 с, 12 с вкл,250 ₽ - Нет в наличииЛеонтьев В.К.
Микробиология и иммунология для стоматологов
Издательство: Практическая медицина. Артикул: 104944, ISBN: 978-5-98811-148-1, год: 2010, страниц: 504 с ил,490 ₽ - Нет в наличииЖулев Е.Н.
Частичные съемные протезы (теория, клиника и лабораторная техника)
Издательство: Медицинское информационное агентство. Артикул: 104954, ISBN: 978-5-8948-1861-0, год: 2011, страниц: 424 с ил,440 ₽ - Нет в наличииА.П. Калинин
Методы визуализации околощитовидных желез и паратиреоидная хирургия
Издательство: Видар-М. Артикул: 104844, ISBN: 978-5-88429-140-9, год: 2010, страниц: 311 с ил,690 ₽ - Нет в наличииМиш К.Е.
Ортопедическое лечение с опорой на дентальные имплантаты
Издательство: Reed Elsevier. Артикул: 104817, ISBN: 978-5-91713-040-8, год: 2010, страниц: 616 с ил,3390 ₽